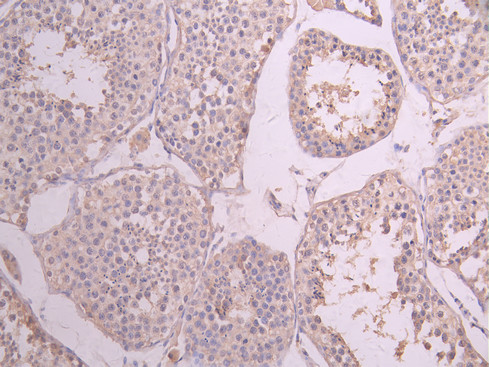

CLU Recombinant Monoclonal Antibody
-
中文名稱:CLU Recombinant Monoclonal Antibody
-
貨號:CSB-RA005595MA2HU
-
規格:¥1320
-
圖片:
-
Western Blot
Positive WB detected in: HeLa whole cell lysate(30μg), HepG2 whole cell lysate(30μg), colo205 whole cell lysate(30μg)
All lanes: Clusterin antibody at 1:1000
Secondary
Goat polyclonal to human IgG at 1/40000 dilution
Predicted band size: 52 kDa
Observed band size: 52 kDa
Exposure time: 30s -
IHC image of CSB-RA005595MA2HU diluted at 1:50 and staining in paraffin-embedded human testis tissue performed on a Leica BondTM system. After dewaxing and hydration, antigen retrieval was mediated by high pressure in a citrate buffer (pH 6.0). Section was blocked with 10% normal goat serum 30min at RT. Then primary antibody (1% BSA) was incubated at 4°C overnight. The primary is detected by a Anti-Human lgG, Fcy Fragment Specific labeled by HRP and visualized using 0.05% DAB.
-
IHC image of CSB-RA005595MA2HU diluted at 1:50 and staining in paraffin-embedded human breast cancer performed on a Leica BondTM system. After dewaxing and hydration, antigen retrieval was mediated by high pressure in a citrate buffer (pH 6.0). Section was blocked with 10% normal goat serum 30min at RT. Then primary antibody (1% BSA) was incubated at 4°C overnight. The primary is detected by a Anti-Human lgG, Fcy Fragment Specific labeled by HRP and visualized using 0.05% DAB.
-
IHC image of CSB-RA005595MA2HU diluted at 1:50 and staining in paraffin-embedded human endometrial cancer performed on a Leica BondTM system. After dewaxing and hydration, antigen retrieval was mediated by high pressure in a citrate buffer (pH 6.0). Section was blocked with 10% normal goat serum 30min at RT. Then primary antibody (1% BSA) was incubated at 4°C overnight. The primary is detected by a Anti-Human lgG, Fcy Fragment Specific labeled by HRP and visualized using 0.05% DAB.
-
Immunofluorescence staining of A549 cell with CSB-RA005595MA2HU at 1:30 ,counter-stained with DAPI. The cells were fixed in 4% formaldehyde, permeabilized using 0.2% Triton X-100 and blocked in 10% normal Goat Serum. The cells were then incubated with the antibody overnight at 4°C. The secondary antibody was Alexa Fluor 488-congugated AffiniPure Goat Anti-Human IgG(H+L).
-
Immunofluorescence staining of Hela cell with CSB-RA005595MA2HU at 1:30 ,counter-stained with DAPI. The cells were fixed in 4% formaldehyde, permeabilized using 0.2% Triton X-100 and blocked in 10% normal Goat Serum. The cells were then incubated with the antibody overnight at 4°C. The secondary antibody was Alexa Fluor 488-congugated AffiniPure Goat Anti-Human IgG(H+L).
-
Overlay Peak curve showing HepG2 cells stained with CSB-RA005595MA2HU (red line) at 1:100. The cells were fixed in 4% formaldehyde and permeated by 0.2% TritonX-100 for 10min. Then 10% normal goat serum to block non-specific protein-protein interactions followed by the antibody (1ug/1*106cells) for 45min at 4℃. The secondary antibody used was Fluorescein (FITC) AffiniPure Goat Anti-Human IgG, Fcγ fragment specific at 1:200 dilution for 35 min at 4℃.Control antibody (green line) was human IgG1 (1ug/1*106cells) used under the same conditions. Acquisition of >10,000 events was performed.
-
-
其他:
產品詳情
-
Uniprot No.:
-
基因名:
-
別名:Clusterin (Aging-associated gene 4 protein) (Apolipoprotein J) (Apo-J) (Complement cytolysis inhibitor) (CLI) (Complement-associated protein SP-40,40) (Ku70-binding protein 1) (NA1/NA2) (Testosterone-repressed prostate message 2) (TRPM-2) [Cleaved into: Clusterin beta chain (ApoJalpha) (Complement cytolysis inhibitor a chain), Clusterin alpha chain (ApoJbeta) (Complement cytolysis inhibitor b chain)], CLU, APOJ CLI KUB1
-
反應種屬:Human
-
免疫原:Recombinant Human CLU protein
-
免疫原種屬:Homo sapiens (Human)
-
標記方式:Non-conjugated
-
克隆類型:Monoclonal
-
抗體亞型:hIgG1
-
純化方式:Affinity-chromatography
-
克隆號:19D11
-
濃度:It differs from different batches. Please contact us to confirm it.
-
保存緩沖液:Preservative: 0.03% Proclin 300
Constituents: 50% Glycerol, 0.01M PBS, PH 7.4 -
產品提供形式:Liquid
-
應用范圍:ELISA, WB, IHC, IF, FC
-
推薦稀釋比:
Application Recommended Dilution WB 1:500-1:2000 IHC 1:50-1:200 IF 1:50-1:200 FC 1:50-1:200 -
Protocols:
-
儲存條件:Upon receipt, store at -20°C or -80°C. Avoid repeated freeze.
-
貨期:Basically, we can dispatch the products out in 1-3 working days after receiving your orders. Delivery time maybe differs from different purchasing way or location, please kindly consult your local distributors for specific delivery time.
-
用途:For Research Use Only. Not for use in diagnostic or therapeutic procedures.
相關產品
靶點詳情
-
功能:Functions as extracellular chaperone that prevents aggregation of non native proteins. Prevents stress-induced aggregation of blood plasma proteins. Inhibits formation of amyloid fibrils by APP, APOC2, B2M, CALCA, CSN3, SNCA and aggregation-prone LYZ variants (in vitro). Does not require ATP. Maintains partially unfolded proteins in a state appropriate for subsequent refolding by other chaperones, such as HSPA8/HSC70. Does not refold proteins by itself. Binding to cell surface receptors triggers internalization of the chaperone-client complex and subsequent lysosomal or proteasomal degradation. Protects cells against apoptosis and against cytolysis by complement. Intracellular forms interact with ubiquitin and SCF (SKP1-CUL1-F-box protein) E3 ubiquitin-protein ligase complexes and promote the ubiquitination and subsequent proteasomal degradation of target proteins. Promotes proteasomal degradation of COMMD1 and IKBKB. Modulates NF-kappa-B transcriptional activity. A mitochondrial form suppresses BAX-dependent release of cytochrome c into the cytoplasm and inhibit apoptosis. Plays a role in the regulation of cell proliferation. An intracellular form suppresses stress-induced apoptosis by stabilizing mitochondrial membrane integrity through interaction with HSPA5. Secreted form does not affect caspase or BAX-mediated intrinsic apoptosis and TNF-induced NF-kappa-B-activity. Secreted form act as an important modulator during neuronal differentiation through interaction with STMN3. Plays a role in the clearance of immune complexes that arise during cell injury.; Does not affect caspase or BAX-mediated intrinsic apoptosis and TNF-induced NF-kappa-B-activity.; Does not affect caspase or BAX-mediated intrinsic apoptosis and TNF-induced NF-kappa-B-activity. Promotes cell death through interaction with BCL2L1 that releases and activates BAX.
-
基因功能參考文獻:
- The plasma levels of septin-9 and clusterin in ovarian cancer patients were abnormally elevated, which might be used as potential candidates of peripheral blood tumor biomarkers for early diagnosis of EOC and septin-9 might be related to distal metastases of EOC. PMID: 29970704
- Data suggest that the potential of clusterin and glutathione synthetase (GSH-S) as platelet biomarkers for early detection of colorectal cancer (CRC) could improve existing screening modalities in clinical application. PMID: 28849249
- recombinant alpha- and beta-chains exhibit structural and functional differences and differ in their sub-cellular localization. PMID: 28120874
- miR-195 improved the sensitivity of resistant prostate cancer cells to docetaxel by suppressing CLU. PMID: 29665645
- The VDR/MEG3/Clusterin signaling pathway may serve as potential therapeutic targets and prognosis biomarkers for colorectal cancer patients in future. PMID: 29628342
- Meta analysis validated the Alzheimer disease protective association for CLU (rs11136000) variants. PMID: 29504051
- that the Clusterin rs11136000 polymorphism C allele is associated with AD susceptibility PMID: 29396813
- clusterin promotes growth and invasion in renal cell carcinoma cells in vitro and in vivo through upregulation of S100A4 PMID: 29400663
- The results showed that secreted CLU was overexpressed in three hepatocellular carcinoma cell lines. The downregulation of CLU by CLU shRNA synergistically increased Sorafenib sensitivity in the Bel7402 and SMMC7721 cells, and potentiated Sorafenib induced cell apoptosis. PMID: 29436591
- Our study showed low clusterin immunostaining in colorectal carcinoma with lack of association with prognostic indicators PMID: 29279586
- This study showed that the 1- and 2-year follow-up, generalized estimating equation analyses of Alzheimer's disease patients revealed that high levels of plasma clusterin at baseline were associated with a significantly larger decrease in Mini-Mental State Examination compared with low levels of plasma clusterin. PMID: 29169407
- plasma level decreases in healthy but not in asthmatic pregnancy and correlates directly with lung function PMID: 29200898
- Downregulation of apoE and apoJ in CSF strongly suggests a critical role of lipid metabolism in the development and progression of Moyamoya disease. PMID: 28843803
- Our study may help to further elucidate the development and progression of non-small cell lung cancer , also it may contribute to the research of therapies targeting sCLU. PMID: 28954633
- Using global proteomic profiling of brain leptomeningeal arteries, this study revealed that clusterin and tissue inhibitor of metalloproteinases-3 increase in leptomeningeal arteries affected by cerebral amyloid angiopathy. PMID: 27543695
- The presence of microbial invasion of the amniotic cavity, intra-amniotic inflammation (IAI), and microbial-associated IAI was characterized by lower amniotic fluid clusterin concentrations in pregnancies complicated by preterm prelabor rupture of membranes. PMID: 27806672
- Our meta-analysis demonstrated that the rs9331888/C> G polymorphism in the clusterin gene might contribute to Alzheimer disease susceptibility especially in Caucasian populations. PMID: 28168383
- these findings revealed that CLU genotypes could probably modulate the cerebral the Abeta loads on imaging and volume of hippocampus PMID: 27229352
- No association for CLU with Alzheimer's disease in south-Indian population. PMID: 28558900
- we confirm that a PEX/Alzheimer's Disease associated risk variant, rs2279590, resides within an enhancer element and regulates the expression of three candidate genes CLU, PTK2B and EPHX2, which were previously known to be modulators in the progression of Alzheimer's Disease. PMID: 28973302
- Silencing the expression of CLU could improve the anticancer efficacy of CPT. PMID: 28064403
- Thus, we suggest that a combination of PI3K/AKT/mTOR inhibitors with V-ATPase inhibitors might be an effective approach for NSCLC treatment. PMID: 29253572
- plasma clusterin was associated with lower volume of the entorhinal cortex, an area that atrophies early in AD. Clusterin could be informative as part of a multi-component preclinical marker for AD PMID: 29324756
- This study demonstrated that Apo J expression preferentially occurs in neurons in brain in patient with Alzheimer's Disease. PMID: 27197790
- Hippocampal shape features derived from the diffeomorphic metric-based shape analysis led to the identification of significant CLU-PICALM interaction effects on hippocampal morphology in young healthy adults, which were not identified by volume measurement and voxel-wise analysis. PMID: 27017968
- CLU-C allele contrubutes to architectural disruptions in resting-state networks in amnestic mild cognitive impairment (aMCI) subjects (i.e., individuals with elevated risk of AD). PMID: 26899953
- A total of 249 epileptic patients and 289 healthy controls were included in this study. Three Clusterin single nucleotide polymorphisms (SNPs: rs11136000, rs9314349, and rs9331949) were selected and genotyped with the SNaPshot assay. Our study failed to detect an association between Clusterin polymorphisms (rs11136000, rs9314349, and rs9331949) and epilepsy in a Han Chinese population. PMID: 28972394
- Subarachnoid hemorrhage is associated with immediate decrease in CSF clusterin concentrations. PMID: 28803177
- Serum ApoJ levels are closely correlated with the magnitude of insulin resistance. PMID: 28986164
- data confirm that the association of psoriatic disease with some comorbidities, especially metabolic and cardiovascular disease, might support the correlation with increased circulating Clu. PMID: 28958138
- blood platelets have a role in amyloid-beta aggregation in cerebral vessels through integrin alphaIIbbeta3-induced outside-in signaling and clusterin release PMID: 27221710
- The results identify Clusterin as a new molecular partner involved in apoptotic cell efferocytosis and suggest a protective role for Clusterin in inflammation and autoimmune diseases. PMID: 27148688
- CLU as novel and promising biomarker for prognosis in patients with chronic HF PMID: 28391884
- FRET and co-IP assays demonstrated that Clu interacted with beta-amyloid peptide, a pathological protein of AD, which suggested a potential effect of SelR and Abeta with the aid of Clu. The interaction between SelR and Clu provides a novel avenue for further study on the mechanism of SelR in AD prevention. PMID: 23805218
- The findings of this study provided further evidence for the CLU risk variant as a candidate gene for Alzheimer disease and may serve as a pre-clinical neuroimaging phenotype of late-onset Alzheimer disease. PMID: 27396407
- Study demonstrate high concentrations of clusterin (CLU) in mucus samples and significantly reduced CLU levels in cases with endometriosis receiving contraception compared to cases with endometriosis without contraception. PMID: 27071964
- Risk-reducing clusterin genotypes protect against the consequences of poor vascular health on executive function performance and change in older adults without dementia. PMID: 27143425
- Addition of the minor allele for rs670139 (MS4A4E), rs9331896 (CLU), and rs12155159 (NME8) was nominally associated with change on the DWRT, DSST, and WFT, respectively, in whites. For rs670139 and rs9331896 the association was only significant in individuals bearing at least one APOE 4 allele in stratified analyses. PMID: 27781389
- CLU expression is related to the cellular type and inversely correlated with the presence of lymph node metastases in medullary thyroid carcinoma. PMID: 28411179
- Melittin is capable of suppressing tumor growth and promoting gemcitabine sensitivity in pancreatic ductal adenocarcinomas by downregulating cholesterol pathway gene CLU. PMID: 28428074
- Data show that ELOVL7, SOCS3, ACSL4 and CLU were upregulated while PRKAR1A and ABCG1 were downregulated in the phlegm-dampness group. PMID: 27928700
- Both CLU and PLXNA4 have been genetically associated with Alzheimer disease (AD) risk and our data thus provide a direct relationship between two AD risk genes. Our data suggest that increasing the levels of PLXNA4 or targeting CLU-PLXNA4 interactions may have therapeutic value in AD. PMID: 27378688
- Although further studies are required to determine how clusterin suppresses non-specific cellular uptake in phagocytes, our data suggest that clusterin plays a key role in the stealth effect of not only pegylated nanoparticles but also non-pegylated nanoparticles. PMID: 27983983
- the initial rapid aggregation of LDL(-) is apparently counterbalanced by the stabilizing effects of minor proteins such as apoA-I and apoJ. These results help identify key determinants for LDL aggregation, fusion and coalescence into lipid droplets in vivo. PMID: 27233433
- The rs9331888 "GG" genotype in patients and the "CC" genotype in controls were significantly higher in non-4 allele carriers of APOE The haplotype analysis showed the CLU "GCG" haplotype was a risk haplotype. PMID: 27076484
- Study explored the common effects of the clusterin (CLU) rs11136000 variant on the default mode network (DMN) in amnestic mild cognitive impairment (aMCI) subjects and remitted geriatric depression (RGD) subjects. The CLU rs11136000 variant could consistently affect the changing of DMN patterns of aMCI and RGD subjects in the frontal cortex. PMID: 28233427
- Findings indicate that in Alzheimer's disease, clusterin increases, particularly in regions with most abundant Abeta, but because the increase does not match the rising level of Abeta42, the molar ratio of clusterin : Abeta42 in those regions falls, probably contributing to Abeta deposition within the tissue PMID: 27248362
- possible local regulatory role for clusterin in the adipose tissue rather than its systemic involvement in the regulation of energy homeostasis PMID: 27070750
- Study identified significant association of the CLU rs9331888 polymorphism with Alzheimer's disease susceptibility in Caucasian population but not in East Asian population (Meta-analysis). PMID: 25633098
- Our results suggest clusterin plays a role in modulating the inflammatory response of acute and chronic traumatic brain injury and that it is a useful marker for TBI, particularly in cases with short survival times. Its prominent accumulation in astrocytes, alongside a mounting inflammatory response and activation of microglial cells supports a potential role in the neurodegenerative changes that occur as a result of TBI. PMID: 27365216
顯示更多
收起更多
-
亞細胞定位:[Isoform 1]: Secreted.; [Isoform 4]: Cytoplasm.; [Isoform 6]: Cytoplasm.; Nucleus. Cytoplasm. Mitochondrion membrane; Peripheral membrane protein; Cytoplasmic side. Cytoplasm, cytosol. Microsome. Endoplasmic reticulum. Mitochondrion. Mitochondrion membrane. Cytoplasm, perinuclear region. Cytoplasmic vesicle, secretory vesicle, chromaffin granule.
-
蛋白家族:Clusterin family
-
組織特異性:Detected in blood plasma, cerebrospinal fluid, milk, seminal plasma and colon mucosa. Detected in the germinal center of colon lymphoid nodules and in colon parasympathetic ganglia of the Auerbach plexus (at protein level). Ubiquitous. Detected in brain,
-
數據庫鏈接:
Most popular with customers
-
YWHAB Recombinant Monoclonal Antibody
Applications: ELISA, WB, IHC, IF, FC
Species Reactivity: Human, Mouse, Rat
-
Phospho-YAP1 (S127) Recombinant Monoclonal Antibody
Applications: ELISA, WB, IHC
Species Reactivity: Human
-
-
-
-
-
VDAC1 Recombinant Monoclonal Antibody
Applications: ELISA, WB, IHC
Species Reactivity: Human, Mouse, Rat
-
VCP Recombinant Monoclonal Antibody
Applications: ELISA, WB, IHC, IF, IP
Species Reactivity: Human, Rat